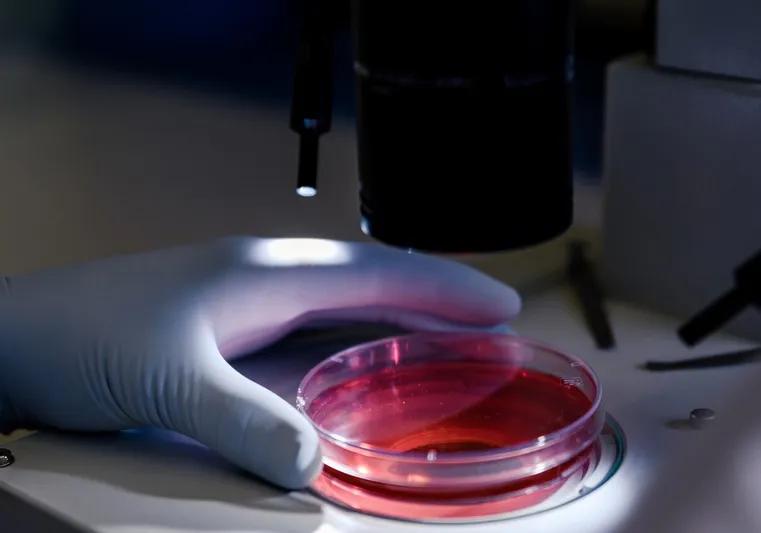
Hematológia

Milyen tünetekkel forduljunk hematológushoz?
Mint az a fentiekből már kiderült: hematológiára a legtöbbször egy általános háziorvosi vagy belgyógyászati rendelést követően kerülnek a betegek. Ennek ellenére vannak olyan tünetek, amelyek főként halmozott megjelenés esetén gyakran utalhatnak arra, hogy a páciensnek hematológiai vizsgálatra van szüksége. Ezek a tünetek a következők:
- rendellenességek a vérképen;
- vashiány és vérszegénység;
- általános és szűnni nem akaró fáradékonyság, gyengeség, rossz közérzet;
- sápatag, gyakran viszkető, kiszáradt bőr, töredezett hajak és körmök;
- gyakori szédülés, fejfájás, migrén, rosszullét, ájulás vagy ájulásközeli állapot;
- folyamatos álmatlanság, alvásproblémák, nyugtalan alvás;
- megnagyobbodott, de nem fájdalmas nyirokcsomók, valamint lép;
- a koncentrációs képesség tartós csökkenése, figyelemzavar.
A hematológián természetesen nemcsak diagnózist várhat a páciens, hanem a már meglévő betegségek kezelését is. Hogy milyen elváltozások tartoznak ehhez a szakághoz? Lássuk a legyakoribbakat:
Vérszegénység
A vérszegénység egy fokozatosan kialakuló betegség, mely sokáig nem okoz tüneteket. Kialakulásakor a vörösvértestek száma határérték alá csökken, amitől a beteg fáradt, sápadt, nem tud koncentrálni, zúg a füle, mindig kimerült és így tovább.
Véralvadási zavar
Véralvadási zavarról akkor beszélünk, ha a szervezetben túl sok vagy túl kevés termelődik a véralvadásért felelős anyagból, amitől a beteg túlzottan vérzékennyé válhat, vagy éppen ellenkezőleg, vérrögök képződhetnek az érrendszerében.
Trombózis
A trombózis a véralvadási zavar egyik következménye, ami gyakran észrevétlenül jelenik meg a szervezeten belül. Részeként az érrendszerben vérrög keletkezik, ami elzárja a vér útját, és ez bizonyos testrészek esetén akár halált is előidézhet.
Leukémia
A leukémia az egyik legsúlyosabb betegség, amivel a hematológia foglalkozik. Daganatos elváltozás, mely a csontvelőt érinti, és a vérkép alapján a fehérvérsejtszám problémája utalhat rá. Sokáig nem okoz tüneteket, később azonban láz, fogyás, megdagadó nyirokcsomók, csontfájdalmak, valamint a lép és a máj duzzanata jelentkezik.
Limfóma
Szintén egy daganatos megbetegedés, ami a nyirokrendszer sejtjeit támadja, ezért azok növekedésnek indulnak, ami látható és érezhető tüneteket produkál. A korai panaszok között a folyamatosan vissza-visszatérő lázas állapot, a gyakori izzadás, a fáradékonyság, a köhögés és az étvágytalanság, valamint a fogyás találhatók.